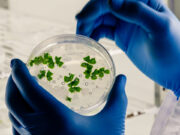
Combatting antimicrobial resistance

The EU and the Indo-Pacific: Partners for a more stable and prosperous world
By Josep Borrell Fontelles
AT the start of 2024, Europeans are of course deeply concerned by the ongoing Russian war of aggression against Ukraine and by the conflict...
The attack on the Mona Lisa’s smile
By Howard Chua-Eoan
“MAIS NON!” gasped at least one visitor recorded on video Sunday morning as two women splashed orange liquid — or soup, as several news...
The Internet Transactions Act and Philippine e-commerce
By Samantha Isabel A. Mendiola
THE Philippine e-commerce market is experiencing continuous growth. E-commerce sales are expected to grow at a compound annual growth rate of 9%.* Against this...
Relevant leadership
By Jaime Augusto Zobel de Ayala
I thank MAP for inviting me to share my thoughts on this topic of relevant leadership. Allow me to share some ideas, as well as some stories on how we at Ayala apply this interpretation of relevant leadership.
The baffling People’s Initiative
By Oscar P. Lagman, Jr.
ACCORDING to Pulse Asia, controlling inflation is the only issue considered as urgent by 72% of Filipino adults. Inflation is the average price increase...
Coal power and higher life expectancy
By Bienvenido S. Oplas, Jr.
AMONG the common arguments against the retention of existing coal power plants in the Philippines and other countries is that coal is polluting and...
Now is the perfect time to change the Constitution
By Calixto V. Chikiamco
NOW is the perfect time to change the Constitution. It’s the perfect time because Ferdinand Marcos, Jr. is president.
It’s the perfect time politically.
President “Bongbong”...
The Maharlika strategic investment fund: Starting with credibility through The Peterson Institute Governance scorecard...
By Alexander C. Escucha
My previous column (https://tinyurl.com/2xbm8mtk) detailed the 24 Santiago principles, or, more specifically, the generally accepted principles and practices (GAPP), to which 15 sovereign funds have signed to commit to such principles and reported the progress of their implementation in a 2014 report.
The ‘invisible hand’ or the ‘visible hand’?
By Eric D. U. Gutierrez
A basic economic concept I learned in school is the “invisible hand” — the metaphor Adam Smith used for the unseen forces of self-interest...
Combatting antimicrobial resistance
By Teodoro B. Padilla
Antimicrobial resistance (AMR) is one of the top global public health and development threats identified by the World Health Organization (WHO). The agency estimated...
Are you guilty of virtue signaling?
By Ron F. Jabal
In recent years, the term “virtue signaling” has infiltrated public discourse, reflecting a phenomenon where individuals or organizations proclaim their commitment to certain values,...
It’s possible, but maybe not likely
By Diwa C. Guinigundo
No, it’s not a simple question of when the Bangko Sentral ng Pilipinas (BSP) and Monetary Board (MB) will finally reverse course and start...